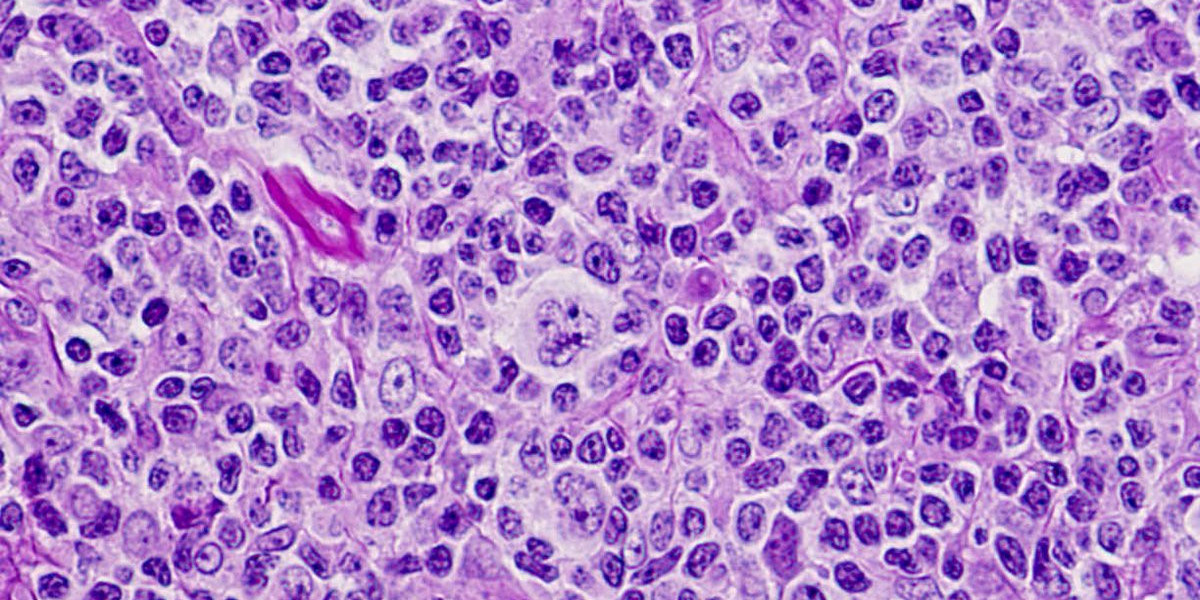
T-Cell Lymphoma: Role Of The Microbiome In Disease Modulation

stop foreclosure fraud
stopforeclosurefraud.com Help Stop Unlawful Foreclosures, Bank Repossession, Evictions and Foreclosure Fraud with the power of Resources, Education and Each Other.
Official Home Of Stop Foreclosure Fraud | Help Stop Unlawful Foreclosures, Bank Repossession, Evictions and Foreclosure Fraud with the power of Resources, Education and Each Other.